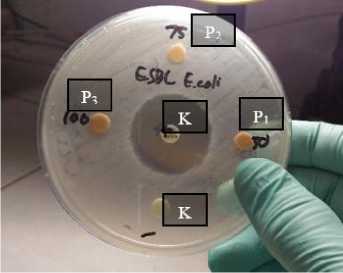

EFEK AKTIVITAS ANTIBAKTERI EKSTRAK SABUT KELAPA (COCOS NUCIFERA L.) VARIETAS DALAM TERHADAP PERTUMBUHAN BAKTERI EXTENDED SPECTRUM ?-LACTAMASE PRODUCING ESCHERICHIA COLI SECARA IN VITRO
on
ISSN: 2597-8012 JURNAL MEDIKA UDAYANA, VOL. 9 NO.4,APRIL, 2020
DOAJ
DIRECTORY OF OPEN ACCESS JOURNALS
Diterima:15-04-2020 Revisi:22-04-2020 Accepted: 29-04-2020
EFEK AKTIVITAS ANTIBAKTERI EKSTRAK SABUT KELAPA (COCOS NUCIFERA L.) VARIETAS DALAM TERHADAP PERTUMBUHAN BAKTERI
EXTENDED SPECTRUM β-LACTAMASE PRODUCING ESCHERICHIA COLI SECARA IN VITRO
I Kadek Aditya Nugraha1, Made Agus Hendrayana2
1Program Studi Pendidikan Dokter, Fakultas Kedokteran Universitas Udayana 2Departemen Mikrobiologi Fakultas Kedokteran Universitas Udayana Koresponding : I Kadek Aditya Nugraha
*Email: kadek_adityanugraha@yahoo.com
ABSTRAK
Escherichia coli (E. coli) merupakan bakteri bersifat non-patogen dan patogen. Meskipun penatalaksaan utama infeksi E. coli adalah pemberian antibiotik, dalam perkembangannya muncul strain E. coli penghasil Extended Spectrum β-lactamase (ESBL). E. coli penghasil ESBL memiliki kemampuan menghidrolisis antibiotik golongan beta-laktam yaitu penisilin; sefalosporin generasi pertama, kedua, dan ketiga; serta aztreonam. Sabut kelapa (Cocos nucifera L.) memiliki fitokimia utama tanin berupa prosianidin serta fenol berupa katekin dan epikatekin yang memiliki aktivitas antibakteri. Kemampuan produksi kelapa varietas dalam di Provinsi Bali adalah 71.754,68 ton per tahun. Jumlah produksi kelapa varietas dalam yang besar menarik peneliti untuk melakukan telaah mengenai aktivitas ekstrak etil asetat sabut kelapa varietas dalam dalam menghambat pertumbuhan E. coli penghasil ESBL. Penelitian dimulai dengan ekstraksi sabut kelapa dengan pelarut etil asetat dengan metode maserasi. Ekstrak kemudian diuji kandungan fitokimia secara kualitatif untuk mengetahui komposisi fitokimia pada ekstrak. Ekstrak dengan konsentrasi 50 mg/ml, 75 mg/ml, dan 100 mg/ml ditanam pada kultur E. coli penghasil ESBL dengan metode disc diffusion dengan kontrol negatif dan kontrol positif yaitu etil asetat 100% dan meropenem. Kultur kemudian diinkubasi selama 18-24 jam di suhu 35±2oC. Hasil uji fitokimia menunjukkan kandungan ekstrak berupa tanin, saponin, dan fenol. Hasil uji antibakteri ekstrak sabut kelapa varietas dalam konsentrasi 50 mg/ml, 75 mg/ml, dan 100 mg/ml tidak ditemukan adanya diameter zona hambat pada kultur. Ekstrak sabut kelapa varietas dalam tidak dapat menghambat pertumbuhan bakteri E. coli penghasil ESBL secara in vitro. Perlu dilakukan penelitian lebih lanjut dengan metode ekstraksi yang lebih murni dan pemberian fitokimia dengan konsentrasi lebih tinggi. Kata Kunci: E. coli penghasil ESBL, Sabut Kelapa, tanin, katekin, epikatekin
ABSTRACT
Escherichia coli (E.coli) can be non-pathogenic or pathogenic. While the mainstay of treatment for E. coli infection is antibiotic, Extended Spectrum β-Lactamase Producing (ESBLp) Escherichia Coli is emerging. It has the ability tp hydrolyze beta-lactam group of antibiotic, such as penicillin, first to third generation cephalosporin, and aztreonam. Coconut (Cocos nucifera L.) husk contains tannin in form of procyanidin and phenolic compound, catechin and epicatechin which show antibacterial activity. Total production of coconut tall varieties in Bali is 71,754.68 ton each year. High production of coconut tall varieties is the main concern to make a research on inhibitory activity of ethyl acetate extract of coconut husk tall varieties on growth of ESBLp – E. coli. Research begin with extraction of coconut husk with ethyl acetate. Phytochemical composition is then analyzed. Antibacterial activity of 50 mg/ml, 75 mg/ml, and 100 mg/ml of extract is tested by disc diffusion method. Phytochemical analysis is positive for tannin, phenol, and saponin. There is no inhibitory zone shown by coconut husk extract with concentration of 50mg/ml, 75 mg/ml, and 100 mg/ml. The research conclude that coconut husk extract
doesn’t inhibit growth of ESBLp – E. coli. It is necessary to choose more effective extraction method to produce and analyze higher phytochemical concentration of extract to inhibit growth of ESBLp – E. coli.
Keywords: ESBLp – E. coli, Coconut Husk, tannin, catechin, epicatechin
PENDAHULUAN
Escherichia coli (E. coli) merupakan salah satu jenis bakteri flora normal yang dapat ditemukan pada usus besar hewan berdarah panas, tidak terkecuali manusia. Meskipun sebagian besar strain dari bakteri ini bersifat non-patogenik, namun terdapat beberapa jenis strain yang bersifat patogen terhadap manusia. Infeksi yang disebabkan dapat berupa infeksi gastrointestinal seperti diare akut dan kronis, disentri, hingga hemorrhagic colitis; maupun ekstra gastrointestinal seperti infeksi saluran kemih, hemolytic uremic syndrome, abses hati, pankreatitis, pneumonia, dan meningitis.1 Meskipun terapi utama infeksi E. coli dengan menggunakan antibiotik, dalam perkembangannya resistensi E. coli terhadap antibiotik mulai bermunculan. Salah satu diantaranya yaitu Extended Spectrum β-lactamase Producing Escherichia coli (E. coli penghasil ESBL). E. coli penghasil ESBL memiliki kemampuan untuk menghidrolisis antiobiotik jenis β-lactam yaitu penisilin; sefalosporin generasi pertama, kedua, dan ketiga; serta aztreonam.2 Di region Asia Pasifik, sebanyak 42.2% infeksi E. coli disebabkan karena E. coli penghasil ESBL.3
Sabut kelapa (Cocos nucifera L.) merupakan bagian mesokarp dari buah kelapa. Sabut kelapa mengandung berbagai jenis alkaloid, flavonoid, tanin berupa prosianidin serta fenol berupa katekin dan epikatekin.4 Ekstrak dari sabut kelapa menunjukkan aktivitas antibakteri terhadap E. coli.5 Katekin dan epikatekin dapat berikatan pada membran sel dari bakteri dan mampu menyebabkan kerusakan pada membran tersebut. Kerusakan ini dapat diakibatkan melalui menurunnya integritas dari membran sitoplasma yang mengakibatkan kebocoran dari komponen sitoplasma bakteri.6 Tanin disebutkan pula memiliki aktivitas dalam meng-inaktivasi adesin, enzim, dan protein transport pada membran sel dari bakteri.7
Indonesia sebagai negara peringkat pertama penghasil buah kelapa dengan rata-rata produksi 15,5 milyar butir per tahun dan produksi sabut sebesar 1,8 juta ton sabut per tahun.8 Untuk Provinsi Bali, total luas lahan untuk tanaman kelapa adalah 74.575 Ha dengan total kemampuan produksi buah kelapa sebanyak 72.949,14 ton. Dari total produksi tersebut, sebanyak 71.754,68 ton merupakan kelapa varietas dalam.9 Dengan ketersediaan bahan baku ekstrak yang besar serta penelitian mengenai aktivitas ekstrak sabut kelapa sebagai antibakteri terhadap E. coli penghasil ESBL masih belum tersedia di literatur, hal tersebut menarik peneliti untuk melaksanakan penelitian awal mengenai aktivitas antibakteri ekstrak sabut kelapa (Cocos nucifera L.)
varietas dalam terhadap pertumbuhan bakteri E. coli penghasil ESBL.
BAHAN DAN METODE
Jenis penelitian ini adalah penelitian true experimental posttest only untuk mengetahui pengaruh ekstrak etil sabut kelapa varietas dalam terhadap pertumbuhan E. coli penghasil ESBL secara in vitro yang kemudian hasil perlakuan dinilai berdasarkan diameter zona hambat yang dihasilkan. Penelitian ini dilaksanakan di Laboratorium Mikrobiologi Fakultas Kedokteran Universitas Udayana yang dilaksanakan pada bulan Juni 2016 – September 2016.
Sampel bakteri yang digunakan dalam penelitian adalah spesimen bakteri E. coli penghasil ESBL. Spesimen E. coli penghasil ESBL merupakan bakteri isolat klinis yang diperoleh dari Instalasi Laboratorium SMF Mikrobiologi Klinik Rumah Sakit Umum Pusat Sanglah, Fakultas Kedokteran Universitas Udayana. Sampel ekstrak sabut kelapa yang digunakan diperoleh dari buah kelapa varietas dalam yang diperoleh dari pengepul buah kelapa yang berada di Pasar Batukandik, Desa Padangsambian, Kota Denpasar.
Ekstraksi sabut kelapa dilakukan dengan metode maserasi dengan pelarut etil asetat. Ekstrak kemudian diuji kandungan fitokimia secara kualitatif untuk mengetahui komposisi fitokimia pada ekstrak. Ekstrak dengan konsentrasi 50 mg/ml, 75 mg/ml, dan 100 mg/ml ditanam pada kultur E. coli penghasil ESBL pada media agar Mueller Hinton dengan metode disc diffusion dengan kontrol negatif dan kontrol positif yaitu etil asetat 100% dan meropenem. Kultur kemudian diinkubasi selama 18-24 jam di suhu 35±2oC. Aktivitas antibakteri ekstrak sabut kelapa terhadap E. coli penghasil ESBL dinilai berdasarkan diameter zona hambat yang dihasilkan yang diukur menggunakan jangka sorong dengan satuan milimeter. Penelitian ini sudah mendapatkan Keterangan Kelaikan Etik Nomor: 1985/UN.14.2/Litbang/2016 tertanggal 24 Agustus 2016.
HASIL
Sebanyak 3 kilogram pembungkus luar buah kelapa yang masih terdiri atas ektokarp dan mesokarp dipisahkan dari batok kelapanya. Bagian sabut kelapa, yaitu mesokarp kemudian dipisahkan dari bagian ektokarp. Sabut kelapa tersebut kemudian dikeringkan untuk menghilangkan kandungan airnya. Sabut kelapa yang sudah kering kemudian dihaluskan untuk menghasilkan serbuk sabut kelapa sebanyak 500 gram. Serbuk tersebut kemudian diekstraksi
dengan menggunakan pelarut etil asetat yang kemudian menghasilkan ekstrak berwujud serbuk berwarna kecoklatan sebanyak 4,8 gram seperti gambar 1.

Gambar 1. Hasil Ekstraksi Sabut Kelapa Varietas Dalam. Ekstrak yang terbentuk berwana coklat dengan wujud serbuk.
Hasil ekstraksi sabut kelapa varietas dalam dengan pelarut etil asetat kemudian dilanjutkan dengan pemeriksaan analisis fitokimia. Pemeriksaan tersebut dilakukan untuk melakukan uji secara kualitatif jenis fitokimia yang terkandung di dalam ekstrak sabut kelapa varietas dalam. Dari pemeriksaan analisis fitokimia, didapatkan tiga jenis kandungan fitokimia yang positif yaitu saponin, tanin, dan fenol. Temuan kandungan tanin dan fenol menunjukkan kesesuaian hasil berdasarkan tinjauan pustaka. Saponin merupakan kandungan tambahan yang ditemukan pada ekstrak tersebut. Pemeriksaan analisis fitokimia memberikan hasil seperti tabel 1.
Tabel 1. Data Hasil Pemeriksaan Analisis Fitokimia dari Ekstrak Sabut Kelapa Varietas Dalam
|
No |
Parameter Pengujian |
Hasil Pengujian |
|
1 |
Alkaloid |
Negatif |
|
2 |
Flavonoid |
Negatif |
|
3 |
Saponin |
Positif |
|
4 |
Tannin |
Positif |
|
5 |
Steroid/Triterpen |
Negatif |
|
6 |
Fenol |
Positif |
Aktivitas antibakteri dinilai berdasarkan diameter zona inhibisi pada kultur. Pada penelitian ini digunakan 5 buah cawan petri dengan inkubasi koloni bakteri E. coli penghasil ESBL sesuai 108 CFU/ml dibuat kekeruhan yang setara dengan 0,5 MacFarland. E. coli penghasil ESBL pada masing-masing cawan petri terbagi menjadi 4 kelompok yakni kontrol negatif (K1) dengan etil asetat 100%, kontrol positif (K2) dengan meropenem, ekstrak sabut kelapa varietas dalam 50 mg/ml (P1), ekstrak sabut kelapa varietas dalam 75 mg/ml (P2), dan ekstrak sabut kelapa varietas dalam 100 mg/ml (P3). Adapun zona hambat yang dihasilkan dapat dilihat pada gambar 2 dan tabel 2.
Hasil pengukuran diameter zona hambat ditemukan aktivitas antibakteri yang negatif pada pertumbuhan E. coli penghasil ESBL pada ketiga konsentrasi ekstrak. Pengukuran diameter zona hambat pada seluruh cawan dengan dengan ketiga konsentrasi ekstrak adalah 0 mm.
Gambar 2. Hasil Uji Ekstrak Etil Asetat Sabut Kelapa Varietas Dalam pada E. coli penghasil ESBL Secara In Vitro. Tidak ditemukan adanya diameter zona hambat pada kelompok P1 (konsentrasi 50 mg/ml), P2 (konsentrasi 75 mg/ml), dan P3 (konsentrasi 100 mg/ml).
Tabel 2. Data Hasil Pengukuran Diameter Zona Hambat Ekstrak Etil Asetat Sabut Kelapa Varietas Dalam terhadap Pertumbuhan Bakteri E. coli penghasil ESBL
|
No. |
K1 (mm) |
K2 (mm) |
P1 (mm) |
P2 (mm) |
P3 (mm) |
|
1 |
0,00 |
29 |
0,00 |
0,00 |
0,00 |
|
2 |
0,00 |
28 |
0,00 |
0,00 |
0,00 |
|
3 |
0,00 |
29 |
0,00 |
0,00 |
0,00 |
|
4 |
0,00 |
28 |
0,00 |
0,00 |
0,00 |
|
5 |
0,00 |
28 |
0,00 |
0,00 |
0,00 |
PEMBAHASAN
Prosedur ekstraksi sabut kelapa menghasilkan ekstrak berwujud serbuk berwarna kecoklatan. Prosedur yang digunakan pada penelitian ini berdasarkan metode yang telah dijelaskan oleh Adebayo dkk10 dengan modifikasi minor. Metode ekstraksi sabut kelapa yang digunakan adalah dengan metode maserasi, karena selain telah terbukti mampu mengekstrak fitokimia yang terkandung di dalam sabut kelapa, metode ini juga metode yang mudah dikerjakan, efisien dan terjangkau dari segi ekonomi. Metode yang digunakan telah terbukti mampu mengekstraksi zat aktif yang terkandung di dalam sabut kelapa
Analisis fitokimia dari ekstrak sabut kelapa memberikan hasil yang positif terhadap tanin, saponin, dan fenol. Hasil tersebut konsisten dengan hasil dari penelitian sebelumnya, dimana tanin merupakan zat yang terdeteksi pada seluruh ekstrak sabut kelapa.11-12 Penelitian lain juga menunjukkan variasi kandungan fitokimia selain tanin pada masing-masing ekstrak seperti alkaloid dan flavonoid
dan glikosida.10-11 Sejauh telaah kepustakaan yang telah peneliti lakukan, penelitian yang menunjukkan kandungan saponin positif pada ekstrak sabut kelapa belum ditemukan.
Ditemukannya variasi kandungan fitokimia pada sabut kelapa dari berbagai penelitian dapat dipengaruhi oleh berbagai faktor. Penggunaan metode maserasi yang merupakan metode ekstraksi konvensional menghasilkan hasil ekstraksi dengan efikasi yang lebih rendah serta adanya potensi polusi dari lingkungan karena menggunakan pelarut dalam volume yang besar serta waktu yang lama dalam proses ekstraksi.13 Pemilihan pelarut juga dapat menentukan jumlah dan rasio kandungan fitokimia yang terekstraksi, sehingga masing-masing fitokimia memiliki jenis pelarut tertentu yang sesuai untuk hasil ekstraksi yang optimal. Ekstraksi dengan menggunakan metanol memberikan hasil ekstraksi yang lebih efisien terhadap fenol dengan berat molekul rendah, sedangkan ekstraksi dengan aseton akuos memberi hasil ekstraksi yang lebih baik terhadap flavanol.14-15
Pada penelitian ini tidak ditemukan adanya aktivitas antibakteri dari ekstrak sabut kelapa varietas dalam terhadap bakteri E. coli penghasil ESBL. Sebagai studi pertama yang meneliti hal tersebut, terdapat beberapa penelitian yang mampu menjadi penjelasan mengenai tidak ditemukannya aktivitas antibakteri tersebut. Proses ekstraksi sabut kelapa varietas dalam pada penelitian ini hanya melalui satu tahap dengan teknik maserasi, dimana teknik tersebut menghasilkan ekstrak yang masih mengandung substrat sampingan seperti karbohidrat dan lemak. Kandungan tambahan tersebut dapat menurunkan konsentrasi fitokimia yang terkandung pada ekstrak. Oleh karena itu dibutuhkan prosedur lanjutan untuk mengeliminasi substrat sampingan tersebut seperti partisi, ekstraksi sekuensial, atau ekstraksi fase padat.13
Fraksinasi adalah salah satu metode partisi yang umum digunakan dalam prosedur ekstraksi. Esquenazi dkk16 menemukan hasil fraksinasi sabut kelapa yang sebelumnya diekstraksi dengan metode maserasi dengan menggunakan kombinasi antara metanol, etil asetat, dan akuades mampu meningkatkan kandungan katekin dalam ekstrak. Metode fraksinasi selain mampu meningkatkan kandungan masing-masing fitokimia dari ekstrak juga terbukti memiliki aktivitas yang berbanding lurus terhadap aktivitas antibakteri sabut kelapa pada bakteri gram positif dan negatif.6,16,17
Meskipun pada hasil ekstraksi menunjukkan adanya kandungan tanin, penelitian lain menunjukkan bahwa konsentrasi dan jenis spesifik dari tanin pada ekstrak akan mempengaruhi aktivitas antibakterinya. Pemberian ekstrak tanin yang diperoleh dari ekstrak tanaman sumac, post oak, shinnery oak, skunk bush dan quebracho dengan dosis 50 mg/ml dan 100 mg/ml secara statistik menunjukkan penigkatan aktivitas antibakteri yang
signifikan (p<0,001) terhadap pertumbuhan E. coli, Streptococcus aureus, dan Klebsiella pneumoniae.18
Sedangkan berdasarkan jenis tanin yang dikandung, terdapat dua golongan tanin yaitu tanin terkondensasi dan tanin terhidrolisa Pada ekstrak sabut kelapa, jenis tanin utama yang terkandung adalah prosianidin polimerik yang tergolong dalam golongan tanin terkondensasi.19 Penelitian oleh Min dkk20 membandingkan aktivitas tanin dari ekstrak chestnut (Castanea sativa) yang mengandung tanin terhidrolisa sebesar 80% dengan ekstrak mimosa (Acacia mearnsii) yang mengandung tanin terkondensasi sebesar 70%. Perbedaan terdapat pada pola inhibisi dimana tanin dari ekstrak mimosa memberikan efek linear dan kuadratik terhadap inhibisi laju pertumbuhan bakteri, sedangkan tanin dari ekstrak chestnut hanya memberikan pola linear. Hasil analisa secara kuantitatif menunjukkan bahwa kandungan ekstrak dengan kandungan tanin yang terhidrolisa yang dominan memberikan respon bakterisidal yang lebih tinggi dibandingkan dengan ekstrak dengan kandungan tanin terkondensasi yang dominan.
Faktor konsentrasi juga berlaku terhadap aktivitas katekin dan epikatekin dalam menghambat pertumbuhan E. coli, dimana pada penelitian yang sama yang dilakukan oleh Min dkk18 menunjukkan peningkatan aktivitas antibakteri dengan katekin dan epikatekin pada dosis 2 mg/ml dan 4 mg/ml yang bermakna secara statistik.
Adanya degradasi zat aktif pada ekstrak juga mempengaruhi aktivitas antibakterinya karena degradasi zat aktif tersebut akan menurunkan kandungan fitokimia pada ekstrak. Degradasi zat aktif dipengaruhi oleh fase atau wujud dari ekstrak, akses dengan udara di lingkungan, dan pemberian zat stabilisator. Ekstrak fase padat, penyimpanan ekstrak pada ruangan yang kedap udara dan kelembaban yang rendah, serta pemberian zat stabilisator pada ekstrak akan menurunkan laju degradasi zat aktif dari ekstrak.21
SIMPULAN
Hasil ekstrak etil asetat sabut kelapa varietas dalam yang dilakukan analisa fitokimia menunjukkan adanya kandungan tanin, fenol, dan saponin. Analisa aktivitas antibakteri ekstrak etil asetat sabut kelapa varietas dalam konsentrasi 50 mg/ml, 75 mg/ml, dan 100 mg/ml tidak dapat menghambat pertumbuhan bakteri E. coli penghasil ESBL secara in vitro.
SARAN
Perlu dilakukan pemilihan dan penggunaan metode ekstraksi yang lebih efektif dibandingkan dengan metode maserasi yang mampu meminimalisasi faktor-faktor pengganggu proses ekstraksi sehingga mampu menghasilkan ekstrak dengan kemurnian dan konsentrasi zat aktif yang lebih maksimal. Lalu pengujian aktivitas ekstrak sabut kelapa varietas dalam dilakukan pada konsentrasi ekstrak yang lebih
tinggi untuk menentukan konsentrasi inhibisi minimal ekstrak untuk menghambat pertumbuhan bakteri E. coli penghasil ESBL. Diperlukan juga penelitian lebih lanjut mengenai kandungan fitokimia ekstrak sabut kelapa varietas dalam secara kuantitatif untuk mendapatkan data yang lebih terperinci mengenai konsentrasi masing-masing kandungan fitokimia sabut kelapa varietas dalam yang berasal dari Provinsi Bali.
DAFTAR PUSTAKA
-
1. Donnenberg MS. Escherichia coli: Pathotypes and Principles of Pathogenesis. London: Elsevier. 2013. H. 30-37.
-
2. Paterson DL dan Bonomo RA. Extended-Spectrum β-lactamases: a Clinical Update. Clin. Microbiol. Rev. 2005; 18(4): 657-86.
-
3. Hawser SP, Bouchillon SK, Hoban DJ, Badal RE, Hsueh PR, Paterson DL. Emergence of High Levels of Extended-Spectrum-β-
lactamase-Producing Gram-Negative Bacilli in the Asia-Pacific Region: Data from the Study for Monitoring Antimicrobial Resistance Trends (SMART) Program. 2007. Antimicrob Agents Chemother. 2009 Aug; 53(8): 3280– 3284
AR, Alviano CS, Farias LM. In vitro
antioxidant potential of medicinal plant extracts and their activities against oral bacteria based on Brazilian folk medicine. Arch Oral Biol. 2008; 53:545–52
-
5. Verma V, Bhardwaj A, Rathi S, Raja RB. A Potential Antimicrobial Agent from Cocos nucifera mesocarp extract; Development of a New Generation Antibiotic. ISCA Journal of Biological Sciences. 2012; Vol. 1(2): 48-54
-
6. Akinpelu DA, Alayande KA, Aiyegoro OA, Akinpelu OF, Okoh AI.. Probable mechanisms of biocidal action of Cocos nucifera Husk extract and fractions on bacteria isolates. BMC Complement Altern Med. 2015; 15: 116-124.
-
7. Cowan MM. Plant Products as Antimicrobial Agents. Clin Microbiol Rev. 1999; 12(4): 564– 582.
-
8. Departemen Pertanian. Prospek Dan Arah Pengembangan Agribisnis Kelapa. Jakarta: Badan Litbang Pertanian. 2007. h. 16-25.
-
9. Dinas Pertanian Provinsi Bali. Statistik Perkebunan Bali 2014. Denpasar: Dinas Pertanian Provinsi Bali. 2015. h. 22-37.
-
10. Adebayo JO, Balogun EA, Malomo SO, Soladoye AO, Olatunji LA, Kolawole OM, Oguntoye OS. Antimalarial Activity of Cocos nucifera Husk Fibre: Further Studies. Evid Based Complement Alternat Med. 2013:742746
-
11. Shettigar R, Lala R, Nandvikar NY. Evaluation of antimicrobial activity of coconut husk
extract. Annals of Applied Bio-sciences. 2014; 1:23-27
-
12. Israel AU dan Eduok UM. Removal of Some Metal Ions from Aqueous Solution Using Coconut Coir Dust and Modified Coconut Coir Dust Extract Resins. Research Journal of Applied Science. 2012; 7 (9-12): 481-488
-
13. Dai J dan Mumper RJ. Plant Phenolics: Extraction, Analysis and Their Antioxidant and Anticancer Properties. Molecules. 2010;15:
7313-7352
-
14. Prior RL, Lazarus SA, Cao G, Muccitelli H, Hammerstone JF. Identification of procyanidins and anthocyanins in blueberries and cranberries (Vaccinium spp.) using highperformance liquid chromatography/mass spectrometry. J. Agric. Food Chem. 2001; 49: 1270-1276
-
15. Labarbe B, Cheynier V, Brossaud F, Souquet JM, Moutounet M. Quantitative fractionation of grape proanthocyanidins according to their degree of polymerization. J. Agric. Food Chem. 1999; 47: 2719-2723.
-
16. Esquenazi D, Wigg MD, Miranda MM, Rodrigues HM, Tostes JB, Rozental S. Antimicrobial and Antiviral Activities of
Polyphenolics from Cocos nucifera Lin..
(Palmae) Husk Fiber Extract. Research in Microbiology. 2002;153: 647-652
-
17. E Silva DO, Martins GR, da Silva AJR, Alviano DS, Nascimento RP, Kaplan MAC. Chemical and Antimicrobial Analysis of Husk Fiber Aqueous Extract from Cocos nucifera L. African Journal of Biotechnology. 2013; 12(18): 2478-2483
-
18. Min BR, Pinchak WE, Merkel R, Walker S, Tomita G, Anderson R. Comparative antimicrobial activity of tannin extracts from perennial plants on mastitis pathogens. Scientific Research and Essay. 2008; Vol.3 (2): 066-073
-
19. Silva RR, Oliveira e Silva D, Fontes HR, Alviano CS, Fernandes PD, Alviano DS. BMC Complement Altern Med. 2013; 13: 107-114.
-
20. Min BR, Pinchak WE, Anderson RC, Callaway TR. Effect of Tannins on the In Vitro Growth of Escherichia coli O157:H7 and In Vivo Growth of Generic Escherichia coli Excreted from Steers. Journal of Food Protection. 2007; 70
(3): 543-550
-
21. Lomovsky IO. Stability of Green Tea Catechins in the Solid Phase and Aqueous Solutions. Chemistry for Sustainable Development. 2012; 20: 215-220
https://ojs.unud.ac.id/index.php/eum
doi:10.24843.MU.2020.V9.i4.P18
110
Discussion and feedback